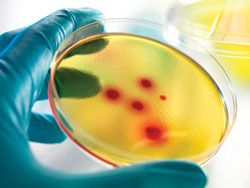
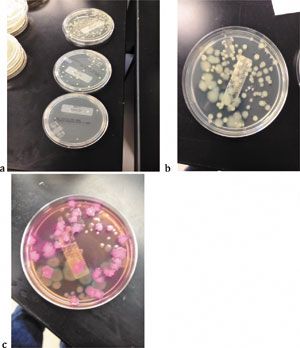

News
Article
Pharmaceutical Technology
Author(s):
The author reports results of evaluations and concludes that a disinfectant composed of a low-concentration suspension of silver ions is completely sporicidal with only a one-minute contact time.
Peer-Reviewed:
Submitted: Aug. 8, 2014. Accepted: Oct. 3, 2014.
AbstractA disinfectant composed of a low-concentration suspension of silver ions is a quick-acting sporicidal disinfectant that is non-corrosive, is skin-safe (non-toxic), and is not a respiratory irritant. The disinfectant was evaluated at the Aseptic Training Institute (ATI) at the Johnston Community College Work Force Development Center in Clayton, NC. Six microbial preparations were used as challenge organisms for the disinfectant on four different surface materials. In addition, the effectiveness of the disinfectant was evaluated in situ by collecting environmental samples after intentionally contaminating and cleaning a facility and equipment. The author reports the results of these evaluations and concludes that the disinfectant is completely sporicidal with only a one-minute contact time.
TEK IMAGE/Science Photo Library/getty images
Silver’s antimicrobial effects have been recognized since ancient times, where it was used in water containers (1). In 1884, the practice of putting silver nitrate drops in newborn’s eyes was introduced to prevent infections caused by
Neisseria gonorrhea
transmitted from infected mothers during childbirth (2). In 1928, the “Katadyn Process” for water purification, which is based on low concentrations of silver in water, was introduced (3). The bactericidal efficacy of silver and its associated ions is through the strong binding with disulfide (S–S) and sulfhydryl (–SH) groups found in the proteins of microbial cell walls. The binding event disrupts normal metabolic processes of the cell, leading to cell death (4). There is also evidence that, after entering a cell, the silver ions displace the hydrogen bonds between adjacent nitrogen molecules of purine and pyrimidine bases, which may stabilize the DNA helix and prevent replication of the DNA and, subsequently, division of the cell (5).
Steriplex, a disinfectant composed of a low concentration (approximately 0.015% by weight) suspension of silver ions was developed after Sept. 11, 2001, in response to the need for a quick-acting sporicidal disinfectant to be used in post offices and other public buildings if potential bioterrorism activity was suspected. It was approved and registered by the US Environmental Protection Agency on April 2, 2010 as an "anthrax disinfectant." It has been used in hospitals for several years and has demonstrated to be effective in reducing the rate of hospital-acquired Clostridium difficile infections. Numerous laboratories, including the microbiology department at Brigham Young University, have evaluated the microbial effectiveness of the product (6, 7).
The formulation for Steriplex SD (sBioMed, Utah) has evolved from these earlier formulations into a two-part system. Part A is composed of a suspension of elemental silver (0.015%) in ethanol, inert food-grade ingredients, and water. Part B is the activator and is composed of hydrogen peroxide, peroxyacetic acid, acetic acid, and water. To prepare the disinfectant suspension, Part B is poured into Part A, which activates the suspended silver ions in Part A. Table I shows the percentages of the combined ingredients when Part A and Part B are mixed.
Table I: Percentage of ingredients in activated Steriplex.
Chemical
Weight %
Silver (elemental)
0.015
Ethanol
10.000
Hydrogen peroxide
0.220
Peroxyacetic acid
0.150
Acetic acid
0.150
Inert food-grade ingredients
0.175
Water
89.290
The evaluations discussed in this article were performed at the Aseptic Training Institute (ATI) at the Johnston Community College Work Force Development Center in Clayton, NC. Known populations of six different microbial suspensions were placed on carriers composed of four different materials commonly found in cleanrooms. The inoculated carriers were then immersed in activated Steriplex SD for one minute. After the one-minute contact time, the carriers were removed and placed in a neutralization broth. The broth and carrier were then rapidly agitated on a vortex mixer to remove any surviving microorganisms. Serial dilutions from the broth were made and different dilutions plated onto growth media to determine the number of survivors and subsequently the log reduction from a positive control. The experimental design was developed from guidance in United States Pharmacopoeia (USP) 37 <1072> (8). A 3-log reduction was specified in the protocol for all evaluations, although USP 37 <1072> suggests “at least a 2-log” reduction for bacterial spores.
Materials and methodsMicroorganisms. Six microbial preparations were used as challenge organisms for the disinfectant on four different surface materials. The following microorganisms were tested: Bacillus cereus, Bacillus megaterium, Bacillus subtilis, Aspergillus niger, a mixture of Staphylococcus aureus (S. aureus) and Staphylococcus epidermidis (S. epidermidis), and a mixture of Escherichia coli (E. coli) and Pseudomonas aeruginosa (P. aeruginosa). Suspensions of the organisms were inoculated onto carriers (approximately 1 x 3 cm). This study included the test material combinations described in Table II.
Table II: Disinfectant efficacy test combinations.
Sanitizer
Steriplex SD (four different lots were tested)
Surface types
316L stainless steel
Polycarbonate used for barrier systems (Lexan 9030, Sabic Innovative Plastics)
Vinyl flooring (Mipolam Symbioz, 6043 Wood, Gerflor USA)
Vinyl flexible curtain material
Bacillus cereus (environmental isolate*)
Bacillus megaterium (environmental isolate*)
Bacillus subtilis (ATCC No. 6633)
aspergillus niger (ATCC No. 16404)
Gram positive cocktail composed of Staphylococcus aureus (ATCC No. 6538) and Staphylococcus epidermidis (ATCC No. 12228)
Gram negative cocktail composed of E. coli (ATCC No. 25922) and P. aeruginosa (ATCC No. 9027)
*Provided by a pharmaceutical company in the Clayton, NC area that supports the Aseptic Training Institute.
Neutralizer broth. After the inoculated carriers were exposed to the disinfectant or saline, they were immediately placed into tubes of Steriplex Neutralization Broth. The following recipe for 100 mL of neutralizer with 1% cysteine was developed by Richard Robison, department chair at the Department of Microbiology, Brigham Young University, Salt Lake City, Utah:
The neutralizer should be made on the day of use, otherwise some of the ingredients will precipitate out of solution over time, especially if stored at a cool temperature. The recipe was prepared using the following steps:
Procedures. Microorganisms were grown on appropriate media and harvested in the log-phase of growth. Bacillus species were grown on AK Sporulation Agar and harvested with sterile 70% isopropyl alcohol (IPA). It was confirmed that the suspension was a uniform spore suspension (no vegetative cells) by performing a spore stain on a sample of the suspension. The Aspergillus was grown on tryptic soy agar (TSA) and harvested with sterile saline containing 0.1% Tween 80. The surfactant enhances removal of the mold mycelia from the agar surface. A four-day culture of mold was harvested and resulted in substantially dispersed mold filaments and/or Aspergillus conidia after vigorous agitation with a vortex mixer. Eighteen-hour cultures of the non-spore-forming bacteria were harvested with sterile saline from TSA plates.
The challenge cultures were enumerated by serial diluting and plate counting using the spread-plate method. Gram negative and gram positive “cocktails” were prepared using mixtures of E. coli and P. aeruginosa for the former and a mixture of S. aureus and S. epidermidis for the latter.
The surface carriers were sterilized by autoclaving. The carriers were processed in a Class II biosafety cabinet. With sterilized forceps, 10 carriers were placed into four individual sterile petri dishes and labeled as the following: Steriplex test article–3 carriers; positive control–3 carriers; neutralization control–3 carriers; and negative control–1 carrier.

As shown in Figure 1, 100 μL of the challenge organism suspension was dispersed onto each of the positive control carriers and each of the test carriers. The suspension was spread evenly on the carriers and air dried in the biosafety cabinet; petri dish covers were left off in the cabinet (see Figure 2).

Processing the carriers. Steriplex-test and neutralization-test carriers (three carriers of each for each microorganism and each surface type) were processed using the following procedure:

Positive and negative control carriers were processed using the following procedure:
Microbial enumeration testing. To test the negative control carriers, 0.1 mL of the negative control neutralizing broth was transferred to each of three sterile TSA plates and the inoculum spread over the surface of each plate.
To test the positive control and test carriers, ten-fold dilutions were made from the neutralizing broth for each positive control and Steriplex-test carrier. The 100 and 10-1 dilution of the Steriplex-test carriers, and the 10-2 through 10-4 dilutions of the positive control carriers were plated. A volume of 0.1 mL of each test dilution was transferred onto each of three TSA plates and the inoculum spread over the surface of each plate (see Figure 4). The gram-negative cocktail test dilutions were tested on a duplicate set of plates containing MacConkey agar, and the gram-positive cocktail dilutions were tested on a separate set of plates containing 5% sheep blood agar.
Neutralization test carriers were tested using the following method, which is based on USP 37 <1227> (9). A volume of 0.1 mL of less than 100 CFU/mL of the test microorganism was transferred into each of the three tubes--2 tubes each containing 4.0 mL of neutralization broth plus carrier and one tube containing 4.0 mL of sterile saline plus carrier. Each tube was then vortexed, and 0.1 mL from each tube was plated onto three TSA plates. The appropriate dilution was calculated from the microbial suspensions prepared as challenge cultures.
As an example, the following procedure would be used for an enumeration culture that contains 107 CFU/mL of B. cereus:
All bacterial plates were incubated at 32 C + 2 °C for 18-48 h. The Aspergillus was incubated at 22 C + 2° C for 48-96 h. When colonies were visibly distinct they were countable.
All plates were counted and the minimum population reduction (efficacy) of the test carriers was determined by subtracting the log of the mean surviving population from the Steriplex-test carriers from the log of the mean surviving population of the positive controls.
Acceptance criteria. For a test to be valid, the average recovery from the positive control carrier must be sufficient to demonstrate the required 3-log reduction. The negative control should not contain presence of growth. For a disinfectant to be efficacious against a test organism, the minimum population reduction must be ≥ 3-log reduction for bacteria, molds, and bacterial spores. The USP now says a 2-log reduction may be appropriate for bacterial spores and fungi. If the duplicate tests are not within 1 log of each other, the test is considered invalid. The acceptance criteria have been selected based on the sterility assurance level (SAL) of 10-3 for a sanitization process. The average count of the neutralization test carriers should be no less than 20% of the count of the saline neutralization control.
Results
The results are summarized in Table III. There was no growth from negative controls. All neutralization evaluations were as expected. The average count from the neutralization tubes was not less than 20% of the counts from the saline control.
Click to Englarge

Since Steriplex Part B is composed of hydrogen peroxide and peroxyacetic acid, the active ingredients in some commonly used sporicides, an evaluation was performed to determine if Part B mixed with water would give similar results as with the activated product. That is, the evaluation was intended to demonstrate that the silver component was critical to the efficacy of activated Steriplex. Steriplex Part B, Lot A was combined with four liters of sterile water and tested on stainless-steel coupons. Only a 1.2-log reduction was achieved compared to a 3.8 log-reduction with the same component used in activated Steriplex.
In-situ evaluations
Hands-on aseptic processing training is offered at the Aseptic Training Institute (ATI) in Clayton, NC. During courses in 2012 and 2013, in-situ evaluations were performed using Steriplex. The ATI facility is a soft-wall cleanroom, approximately 450 ft2 in space. Specific Bacillus spores were intentionally used to contaminate surfaces, materials, and operator’s sterile gloves during media fills performed in the cleanroom at the facility. To evaluate the effectiveness of Steriplex in situ after the facility and equipment had been contaminated and subsequently cleaned with a detergent solution, environmental samples from surfaces of equipment and the facility were collected. The facility and equipment were then sanitized once with Steriplex SD and sampled again. The results are shown in Table IV. The in-situ testing has been performed three times with similar results.
Discussion and conclusion
The data demonstrate anywhere from a 3+ log reduction to over 6+ log reduction of bacterial spores, mold, and both gram-negative and gram-positive bacteria with a one-minute contact time. The in-situ data demonstrate that the product was extremely effective and nonoffensive with regard to operator comfort and health in the workplace.
Activated Steriplex has been used directly on hands as a hand sanitizer in the ATI laboratory. During sanitization of the entire cleanroom and filling equipment at the ATI, there is an aroma and slight eye burning during the process (mainly due to the exhausts from the cleanroom being just louvers in the wall where air from inside the cleanroom is pushed out to the adjoining laboratory). That mild irritation vanishes in 15-20 min. However, there are none of the health and safety concerns as there are with the commonly used sporicidal disinfectants containing higher concentrations of chlorine, hydrogen peroxide, and/or peroxyacetic acid.
A one-minute contact time for any chemical that is sporicidal is revolutionary. Many company standard operating procedures specify contact times of 5, 10, 15, or even 30 minutes. To actually maintain a wet surface in a cleanroom for those long periods of time is impossible unless someone is actually applying the disinfectant throughout that timeframe. Verification of the one-minute contact time is therefore extremely important.
Table IV: Results of in-situ testing; RODAC is replicate organism detection and counting plates.
Location/sample type
Number sampled
Number positive
% positive
Number mold
% mold
Baseline after detergent cleaning, prior to sanitization
RODACs
150
106*
71
47
31
Swabs
32
15
47
1
3
After sanitization with Steriplex
RODACs and swabs
100
0
0
0
0
*mostly spreaders-Bacillus species
One of the most noteworthy features of Steriplex is that it is non-corrosive. That means it could be used daily with no damage to equipment. Ten 316L stainless-steel coupons have been immersed in activated Steriplex at ATI for eight months, and there is no corrosion or rust.
Our data indicate that Steriplex is completely sporicidal with only a one-minute contact time, which should be achievable in any cleanroom. The product can be sprayed, wiped, mopped, or fogged onto surfaces. All data indicates that the product is safe and will not damage equipment or facilities.
References
About the Author
John M. Lindsay is president of Aseptic Solutions and of the Aseptic Training Institute, jlindsay@asepticsolutions.com.
All figures are courtesy of the author.
Article DetailsPharmaceutical Technology
Vol. 39, No. 5
Pages: 42-48
Citation: When referring to this article, please cite it as J. Lindsay, “Evaluating Disinfectant Efficacy of a Silver-Based Disinfectant,” Pharmaceutical Technology 39 (5) 2015.
Get the essential updates shaping the future of pharma manufacturing and compliance—subscribe today to Pharmaceutical Technology and never miss a breakthrough.